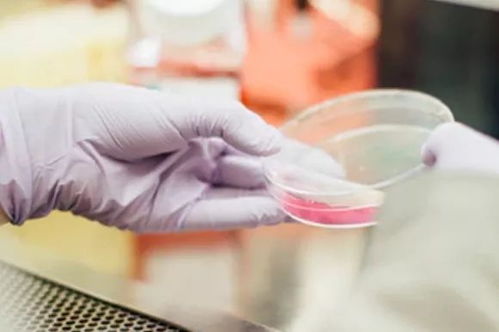
宝宝两个月了还有黄疸怎么办 宝宝两个月了还有黄疸怎么办

宝宝两个月了还有黄疸怎么办
生活常识 2025-12-06 09:40生活常识www.pifubingw.cn
宝宝两个月黄疸不退:应对与关注
当宝宝进入人生的第二个月,黄疸本应逐渐消退。如果发现宝宝仍然面临黄疸问题,家长们不必过于焦虑。我们需要了解黄疸的性质以及应对措施。
一、黄疸概述
黄疸是指血中总胆红素过高,导致皮肤呈现肉眼可见的黄色。对于大多数早产儿和足月儿来说,出生后出现的生理性黄疸是正常现象,无需特殊处理。如果黄疸在宝宝两个月时仍未消退,那就可能是病理性黄疸了。
二、应对策略
1. 查找原因:对于持续不退的黄疸,首先要做的就是寻找原因。可能需要带宝宝去医院进行肝功能检查以及宫内感染的筛查。
2. 饮食与日常护理:在日常生活中,应保证宝宝充足的奶水摄入,同时增加晒太阳的时间,这都有助于黄疸的消退。
3. 药物治疗:在医生的建议下,可能会使用茵栀黄口服液以及药品级的益生菌来帮助宝宝消退黄疸。
4. 住院治疗:如果黄疸情况严重,可能还需要进行住院治疗。这时,家长应积极配合医生的治疗方案,以便宝宝能够尽快康复。
三、温馨提示
面对宝宝黄疸不退的情况,家长应保持冷静,尽可能多地了解相关信息。要密切关注宝宝的身体状况,如有异常,应及时就医。
希望所有面临黄疸问题的宝宝们都能早日康复,健康快乐地成长。每个宝宝都是家庭的希望和未来,让我们一同为他们的健康保驾护航。
上一篇:规矩于和伟 剧说于和伟
下一篇:没有了